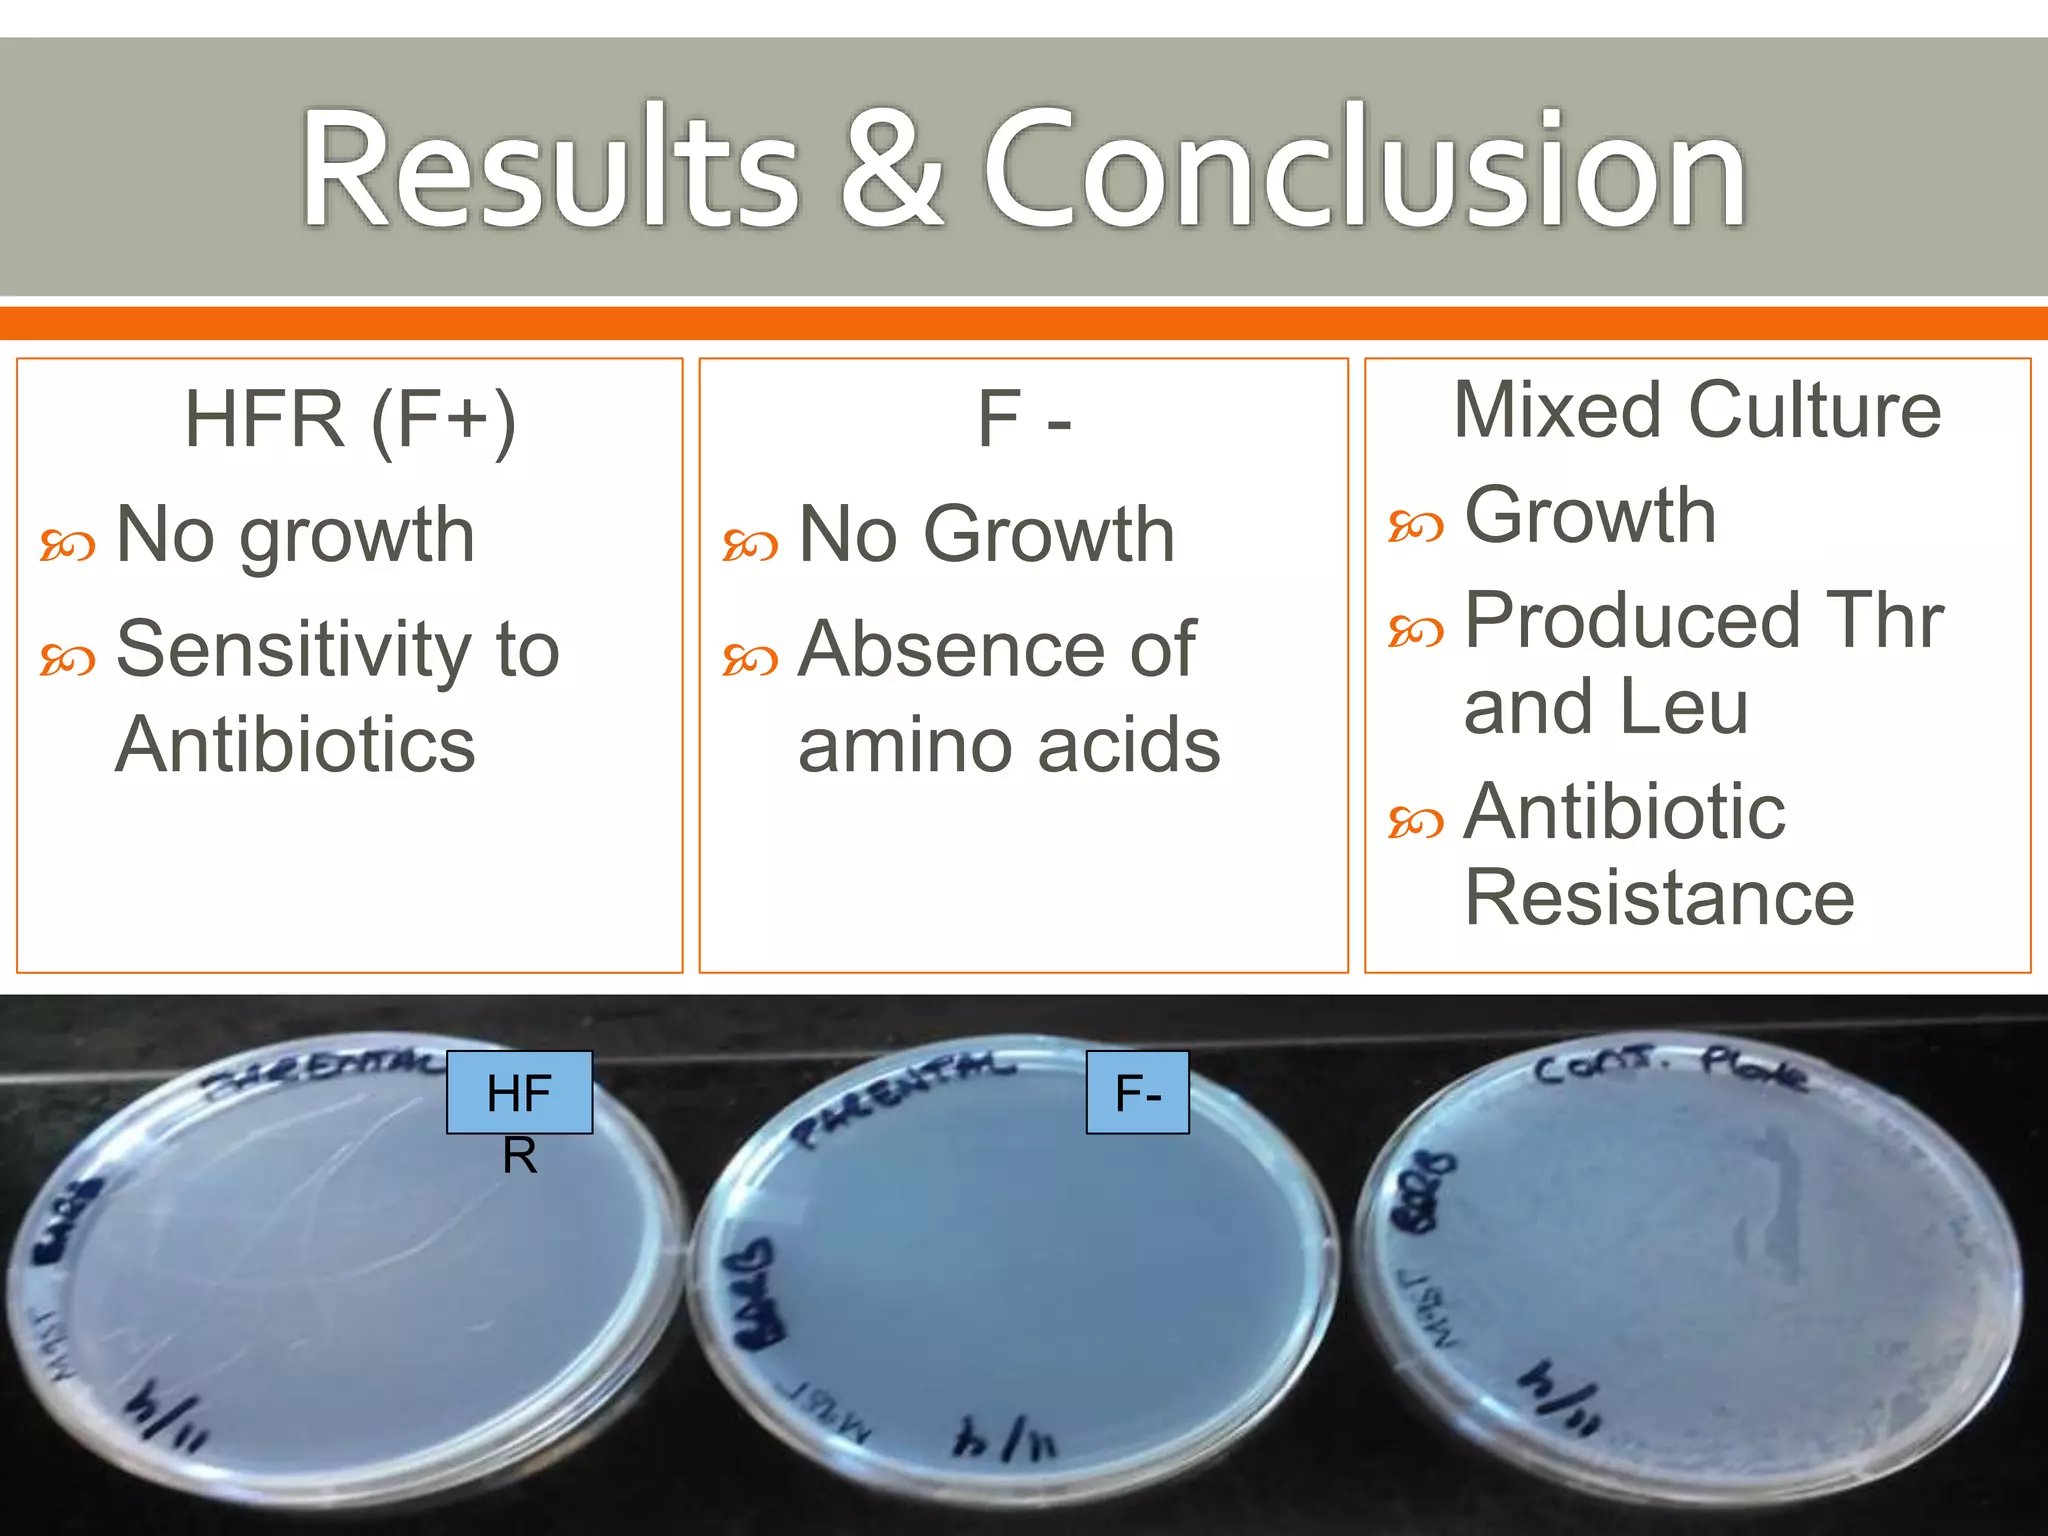
HFR (F+) 
 No growth 
 Sensitivity to 
Antibiotics 
F - 
 No Growth 
 Absence of 
amino acids 
Mixed Culture 
 Growth 
 Produced Thr 
and Leu 
 Antibiotic 
Resistance 
HF F-R

This document discusses genetic variability and horizontal gene transfer in prokaryotes. It describes three main mechanisms of horizontal gene transfer - transduction, transformation, and conjugation. Conjugation involves the transfer of genetic material between bacteria through direct cell-to-cell contact via pilus. The process of conjugation is described, where the F+ donor cell transfers single-stranded DNA to the F- recipient cell. If the transfer is successful, it results in production of F+ recombinants that can serve as donor cells for further conjugation. An experiment demonstrating conjugation between HFR and F- E. coli strains on selective media is also summarized.